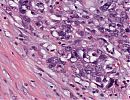

74-jähriger Patient mit diagnostiziertem Magenkarzinom
Anamnese
Im Rahmen einer Schwindel-Abklärung in einem auswärtigen Haus zeigte sich bei Herr M. in einer Gastroskopie ein großer, hochgradig tumorverdächtiger Befund im Pylorusbereich.
Diagnostik
PE: Histologisch konnte in der Magenbiopsie ein mittelgradig differenziertes Adenokarzinom vom interstinalen Typ nachgewiesen werden.
Umfelddiagnostik: In der ebenfalls auswärts durchgeführten Umfelddiagnostik mittels CT-Abdomen konnten kein Hinweise auf ein organüberschreitendes Tumorwachstum, pathologische Lymphknotenvergrößerungen oder eine Fernmetastasierung gefunden werden.
Es wurde die Indikation zur Gastrektomie gestellt.
Explorative Laparotomie: Bei der Exploration des Abdomens tastet sich ein großer derber Tumor im Bereich des Magenkorpus und Pylorus. Weiterhin stellt sich eine beginnende Tumorinfiltration des Pankreaskopfes sowie ein die Serosa durchbrechender pathologischer Lymphknoten im Bereich des Truncus coeliacus und am Pankreasoberrand dar. Aufgrund des lokal fortgeschrittenen Tumorwachstums mit V.a. Lymphknoten-Metastasierung (die Serosa durchbrechende pathologische Lymphknoten im Bereich des Truncus coeliacus) wurde die Indikation zur neoadjuvanten Chemotherapie zum Downstaging gestellt und die Operation damit beendet.
Weiteres therapeutisches Vorgehen
Es folgten 4. Zyklen neoadjuvante Chemotherapie (FluOx-Schema).
Nach 2 Zyklen berichtete der Patient erstmals über Teerstühle. Klinische Symptome traten nicht auf. Der Hb-Wert fiel von 13,3 auf 9,6 g/dl, stabilisierte sich dann jedoch. Eine Kontrollgastroskopie zeigte den bekannten großen malignen ulzerierten Tumor im Pylorus sowie Blut und Koagel jedoch keine Hinweise auf eine aktive Blutung. Eine Koloskopie ergab keine Auffälligkeiten.


Bei der Kontrollgastroskopie nach erfolgter neoadjuvanter Chemotherapie fand sich an der Z-Linie sich eine fibrinbedeckte Erosion, am ehesten einer Mallory-Weiss-Läsion entsprechend. Bei weiterem Vorschieben des Gerätes ist der Magen gut einsehbar. Das Faltenrelief ist normal, es besteht eine ausreichende Peristaltik. Im Antrum ist die Schleimhaut direkt am Pylorus etwas vergröbert. Im Pylorus findet sich das große malignes Ulkus, teils fibrin-, teils koagelbedeckt.


Nach abgeschlossener neoadjuvanter Chemotherapie und erfolgreichem Downstaging wurde erneut die Indikation zur operativen Exploration gestellt.
Procedere
Expl. Laparotomie, hohe B-II-Resektion, Pankreaskapselresektion im Kopfbereich, Cholezystektomie mit Gastrojejunostomie und CHE. Die Leber zeigte keine Hinweise auf Metastasierung, ebenso kein Anhalt für eine Peritonealkarzinose.
Makroskopie
Magenteilresektat mit einem ca. 1,8 cm durchmessenden ulzerierten Tumor. Die Serosa ist oberflächlich fein granulär belegt, die übrige Schleimhaut zeigt keine Veränderungen.
Diagnose
Ulzeriertes Adenokarzinom des Magens vom intestinalen Typ mit regionärer lymphogener Metastasierung.
Mikroskopie
Erkennbar ist ein Abbruch der normalen Magenschleimhaut und der Übergang in eine ulzeröse Läsion. Hier findet man eine ausgedehnte Nekrose, die von zahlreichen Lymphozyten umgeben ist, vor. Das ulzerierte Adenokarzinom (intestinaler Typ nach Lauren) zeigt geringgradige regressive Veränderungen. Zur Tiefe hin erreichen die Tumorinfiltrate breitflächig das subseröse Fettgewebe sowie das anhängende Pankreasgewebe. Der proximale und distale Präparaterand zeigen sich tumorfrei. Im Präparat finden sich insgesamt 6 Lymphknotenmetastasen (von insgesamt 11 LK) sowie eine weitere Lymphknotenmetastase (von insgesamt 3 LK) im Ligamentum hepatoduodenale/Truncus coeliacus.
Virtuelle Mikroskopie
Tumorstadium: ypT2b, ypN2(7/14), M0
R-Klassifikation: R0
Klinischer Verlauf:
In Anbetracht der hohen Anzahl positiver Lymphknoten bei insgesamt nur 14 histopathologisch untersuchten Lymphknoten sowie gutem Allgemeinzustand des Patienten und gut verträglicher sowie ebenso gut ansprechender Chemotherapie nach dem FLUOX-Schema wurde die Durchführung einer adjuvanten Chemotherapie nach dem FLUOX-Schema für 8 Zyklen empfohlen. Diese erfolgte ein Vierteljahr nach der Operation.
Ein halbes Jahr post OP nach erfolgter Chemotherapie stellte sich Herr M. zur Tumornachsorge in der Klinik vor. Hier wurde im Rahmen des Kontrollstagings via Bildgebung die Erstdiagnose einer hepatischen und lymphatischen Metastasierung gestellt.
CT Thorax: Kein Hinweis für Pneumothorax oder Pleuraerguß. Im Lungenfenster keine pneumonischen Infiltrate, kein Nachweis suspekter intrapulmonaler Rundherde.
CT Abdomen: Neu aufgetretene, teils hyperperfundierte Leberläsioen in den Segmenten 2 ( exemplarisch mit 2,7 × 3,1 cm), Segment 5 (bis maximal 2,1 × 2,2 cm) und 6. Weiterhin größenprogredienter Lymphknoten an der kleinen Magenkurvatur mit 1,9 cm. Vermehrte paraaortale und mesenteriale Lymphknoten, teils kalzifiziert im Verlauf konstant. Kein Hinweis auf ein lokales Rezidiv.
Labor: Die Tumormarker sind im Verlauf deutlich angestiegen
Aufgrund der neu aufgetretenen Fernmetastasierung wurde eine Therapieumstellung in die Wege geleitet: Beginn einer palliativen Chemotherapie nach dem Folfiri-Schema, bestehend aus 5-FU, Folinsäure und Irinotecan.
Nach 4 Zyklen Chemotherapie nach dem Folfiri-Schema (5-FU, Folinsäure und Irinotecan) zeigte sich eine stabile Erkrankung mit unveränderten Lebermetastasen sowie größenregredienten Lymphknoten an der kleinen Kurvatur des Magens.
Das Re-Staging ein Dreivierteljahr postoperativ zeigte keinen weiteren Progress.
Labor: Die Tumormarker sind im Verlauf weiter angestiegen.
CT Thorax: unverändert
CT Abdomen: Im Verlauf Nachweis von multiplen Leberläsionen in allen Segmenten, z.B. im Segment 7 der Leber aktuell mit 16 × 19 mm im Verlauf konstant.
Nachweis von Lymphknoten an der kleinen Magenkurvatur aktuell 9 × 11 mm, in der Voruntersuchung 13 × 17 mm, im Verlauf also größenregredient. Vermehrte Lymphknoten intra- und retroperitoneal im Verlauf konstant, teilweise kalzifiziert. Keine freie Flüssigkeit, keine Hämatome, kein Abszeß.
Es bestand gemäß den RECIST-Kriterien eine “stable disease”. Es folgte die zweite Runde mit 4 Zyklen Chemotherapie nach dem Folfiri-Schema.
| Tumormarker | Normbereich | 23.04.07 | 20.07.07 | 18.11.07 | 08.03.08 | 15.05.08 |
|---|---|---|---|---|---|---|
| CA 19-9 | bis 38,0 U/ml | 3,6 | 4,1 | 16,2 | 19,8 | 35,0 |
| CA 72-4 | bis 4 U/ml | 3,19 | 24,38 | 31,64 | 105,3 | |
| CEA | bis 2,5 g/l | 4,0 | 4,9 | 5,9 | 14,6 | 15,2 |
Bei der Nachsorgeuntersuchung ein Jahr postoperativ stellte sich ein Progress der Erkrankung heraus.
CT Thorax: unverändert, kein Hinweis auf pulmonale oder ossäre Metastasen.
CT Abdomen: Im Verlauf an Größe und Ausdehnung progrediente Lebermetastasierung in sämtlichen Lappen, hypodens und unscharf vom Lebergewebe abgrenzbar, der ausgedehnteste Befund findet sich im linken Leberlappen von 5,5 × 3,6 cm. Keine Cholestase. Regelrechte Darstellung der Magenwand im Bereich des Resektionsgebietes. Keine suspekte Weichgewebsvermehrung. Unverändert zahlenmäßig vermehrte Lymphknoten entlang der kleinen Magenkurvatur, retroperitoneal und mesenterial. Große kalzifizierte mesenteriale Lymphknoten bis 3 cm. Kein Hinweis auf ein lokales Rezidiv.
Labor: Tumormarker im Verlauf ansteigend.
Aufgrund der progredienten Erkrankung wurden die Umstellung des bisherigen Chemotherapieschemas auf Docetaxel 35 mg/m2 1xwöchentlich beschlossen welche einen Monat später komplikationlos erfolgte.
Klinische Korrelation
Therapieschema: FLU/Ox (Folfox Magen)
- Oxaliplatin 85 mg/m2 i.v. Tag 1 in 500 ml 5% Glucose über 2 h
- Folinsäure 500 mg/m2 i.v. Tag 1 über 2 h
- 5-Fluorouracil 2600 mg/m2 i.v. Tag 1-2 über 24 h Pumpe
Wiederholung Tag 15
Cave: Neurotoxizität, Hämatotoxizität
Kumulative Gesamtdosis von Oxaliplatin ca. 900 mg/m2 KÖF
Begleittherapie:
Tag 1: Granisetron (Kevatril) 2 mg p.o., Dexamethason (Fortecortin) 8-16 mg p.o. oder i.v.
Tage 2-4: MCP ret. 30 mg 2 x täglich p.o., ggf. Dexamethason (Fortecortin) 4-8 mg p.o.
Staging jeweils nach 4 Zyklen.
Kasuistiken Mikro

Bilder
Abb. 167:

Abb. 168: Magenkarzinom vom intestinalen Typ nach Lauren. Charakteristisch ist ein expansives Wachstum mit Drüsenbildung.
Magen - weitere Kasuistiken
Related articlesMagen - Literatur
Organpathologie-Atlas